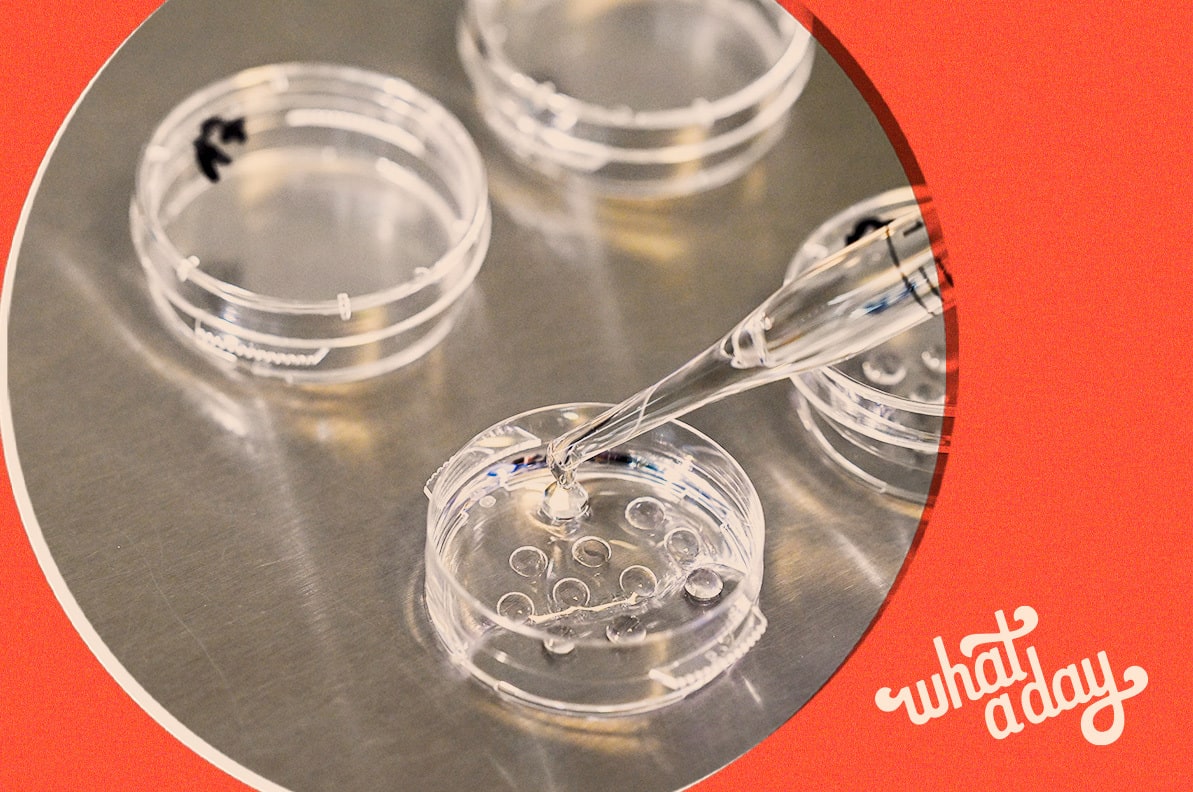

In This Episode
- The University of Alabama health system became the first organization in the state to pause IVF treatments following the Alabama Supreme Court ruling that said frozen embryos can legally be considered “children.” Meanwhile, the future of IVF in the ten other states remains unclear as well because, like Alabama, they say life begins at fertilization. To learn more about how this fits into the larger fight for reproductive rights, we spoke with Dana Sussman, deputy executive director of Pregnancy Justice.
- Nex Benedict, a 16-year-old nonbinary student in Oklahoma, died earlier this month one day after a fight in a school bathroom. The circumstances of Benedict’s tragic death are still coming into focus. But one thing’s for sure: the efforts of anti-LGBTQ lawmakers in Oklahoma, as well as influential right-wing social media accounts like Libs of TikTok, have helped create an extremely hostile environment for trans youth and LGBTQ people in the state.
- And in headlines: the White House wiped out another $1.2 billion in student debt, the latest on the sputtering Republican-led Biden impeachment inquiry, and the Boeing executive in charge of 737 Max’s is out.
Show Notes:
- Pregnancy Justice – https://www.pregnancyjusticeus.org/
- The Independent: “Oklahoma banned trans students from bathrooms. Now a bullied student is dead after a fight” – http://tinyurl.com/2ck7rqso
- Anti-Violence Project’s Hotline for LGBTQ+ Survivors of Violence – Call/Text 212.714.1141
- Gay, Lesbian & Straight Education Network – https://www.glsen.org/
- What A Day – YouTube – https://www.youtube.com/@whatadaypodcast
- Follow us on Instagram – https://www.instagram.com/crookedmedia/
TRANSCRIPT
Priyanka Aribindi: It’s Thursday, February 22nd. I’m Priyanka Aribindi.
Juanita Tolliver: And I’m Juanita Tolliver and this is What a Day, celebrating Beyonce’s achievement as the first Black woman to top the country charts, but trying to get ourselves on the country charts too, you know.
Priyanka Aribindi: Yeah, we might do the news in bolo ties today. Hopefully that is enough to get us there.
Juanita Tolliver: Friend. I’m pretty sure it won’t be enough. [laughing] [music break] On today’s show, we dig into the death of 16 year old non-binary student Nex Benedict in Oklahoma, who died earlier this month, one day after a school fight. Plus, President Biden canceled even more student loan debt yesterday, $1.2 billion worth.
Priyanka Aribindi: But first, a Post Roe world has thrown fertility services into question recently, potentially all over the country. That is because of the Alabama Supreme Court’s ruling last Friday that said that frozen embryos can legally be considered children, and that anyone who destroys them can be held liable for wrongful death.
Juanita Tolliver: Truly an unhinged ruling. But it’s all because of a case involving a patient who inadvertently destroyed embryos at an IVF clinic. And now at least one provider said it’ll stop services altogether.
Priyanka Aribindi: The University of Alabama Health System became the first organization in the state to pause IVF treatment. In a statement issued yesterday, they said that they, quote, “must evaluate the potential that our patients and our physicians could be prosecuted criminally or face punitive damages for following the standard of care for IVF treatments.” And a statement from Alabama’s medical association yesterday cautioned that other health systems in the state will likely follow suit.
Juanita Tolliver: What kind of impact has this been having on people and families experiencing infertility, or any of the other reasons that would prompt them to pursue IVF to have a child?
Priyanka Aribindi: This has been very recent, but it’s not good to say the very least. NBC spoke with Gabby Goidel, a woman in Alabama currently undergoing fertility treatments after suffering from three miscarriages about this decision. Take a listen to what she had to say.
[clip of Gabby Goidel] We’re this very traditional family that just wants to have a kid. I don’t necessarily want to implant a child that I know is going to miscarry, so what does that mean? My main worry is what are we going to do with the ones that are genetically abnormal and–
Juanita Tolliver: Oh wow.
[clip of Gabby Goidel] –what does this mean if my clinic shuts down? I never envisioned that anybody would question the morality of IVF. And now it’s very scary.
Juanita Tolliver: Wow.
Priyanka Aribindi: Very, very scary indeed. This decision is specific to Alabama right now, but ten other states also consider life to begin at fertilization. So this move could have broader implications for the embryos at IVF clinics there, as well as all the people and prospective parents who–
Juanita Tolliver: Right.
Priyanka Aribindi: –are hoping to go down this route to treat infertility. To learn more about this and how it fits into the larger fight for reproductive rights, I spoke earlier with Dana Sussman. She is the deputy executive director at Pregnancy Justice, which is an organization that fights against pregnancy criminalization, mostly in Alabama. I started off by asking her what’s happened since this decision came down in Alabama, and how it impacts people seeking fertility treatment.
Dana Sussman: We’ve already seen reports of providers of IVF care pausing their services while their legal teams assess the risk of pursuing continued treatments for their patients. And so, you know, you see a lot of parallels to what happened in the immediate aftermath of Dobbs, as we’re seeing right now in Alabama.
Priyanka Aribindi: If you were to speak to an IVF patient in Alabama right now, maybe has embryos at this point and has seen this decision and really feeling like they have no idea what this means for them, what would you tell them?
Dana Sussman: I don’t often talk about this, but I also went through IVF and have two beautiful children as a result, I went through the process several years ago in New York. And we have embryos that remain frozen in New York. I would share my my deep empathy with them. I don’t think I’ll ever experience anything like it again. You know, just the stress and the deep sadness that comes with, you know, not knowing if you’ll be a parent, not knowing if you’ll be able to have your own children. The highs and lows and the joys of having a successful pregnancy and really not taking anything for granted. It is incredibly hard, time consuming, expensive and painful. I just want people to know that their providers are probably doing the best they can under incredibly difficult circumstances, and that if you are in Alabama and you are upset by this ruling, the Alabama Supreme Court offered that the legislature would be the place to address this, to consider public policy. But I think that if enough people are upset, are disillusioned, are worried in the state, then pressure on the lawmakers to pass a law protecting IVF would be the next order of business.
Priyanka Aribindi: Right. And even to zoom out further, can you just walk us through how, from a legal perspective, this ruling makes the definition of a person a quote unquote “person” very murky for prospective parents, clinics, law and legal enforcement? Just everybody.
Dana Sussman: We’ve been analyzing the impact of fetal personhood. It doesn’t just impact abortion. It doesn’t just impact folks who are pregnant, but it does also have these major impacts on access to IVF. Because, again, if an embryo is a person, what does that mean for discarding of those embryos, for storage of those embryos? And then there’s all these other implications for both civil and criminal law that are vast and that are are really alarming. You know, for folks like us who have been watching the Alabama Supreme Court and other state supreme courts and legislatures over the last couple decades, this was not actually as frankly surprising as I think it has felt to a lot of people. The reason for that is that this has been an orchestrated and organized movement towards fetal personhood that began in basically the days after the Roe decision in the ’70s. And in Alabama, that has taken shape through a Supreme Court decision, the same Supreme Court that issued this ruling last week from 2013 that designated that child abuse laws could apply to fetuses, um at any point during one’s pregnancy so one could be pregnant and expose their fetus to some risk of harm during pregnancy and be charged with criminal child abuse. And this court cited that decision in making the determination this time that they’re going to expand the law beyond fetuses to include embryos that are not even within a pregnant person’s body. So we have seen this progression in the state for several decades now. It started with criminalization, um which exists in other states as well, uh mostly in the South, but has happened across the country and now is expanding even further.
Priyanka Aribindi: Yes. So you at the Pregnancy Justice Center work on filing lawsuits and gathering legal resources to protect people from pregnancy criminalization. And a lot of that work has been centered in Alabama itself. What are some other questions that are coming in from folks that are both tougher and easier to answer about this?
Dana Sussman: Without the protections of Roe, without abortion as a fundamental right, these fetal personhood laws can be implemented in all sorts of ways. In Georgia, for example, you can claim a tax credit for pregnancy I think at six weeks or later. As we sort of assess the impact of fetal personhood laws, this is the first state Supreme Court that has really taken that post Dobbs framework and applied it and used their fetal personhood law. It’s actually a constitutional amendment in Alabama and applied it in this way. And we have great concerns that this is just sort of the first and that there will be others that follow. I am hopeful on some level, that people who have personally been impacted by infertility, that have benefited from IVF, which is a true sort of like miracle of science, this will galvanize people to sort of see the connection between abortion and pregnancy and IVF, and that we need to be fighting sort of across these, these different issues together.
Priyanka Aribindi: That was my conversation with Dana Sussman, deputy executive director at Pregnancy Justice. We will link to their website in our show notes.
Juanita Tolliver: Yeah, I’m so glad you were able to have that conversation, because my biggest fear is how this decision jump starts the broader anti-abortion agenda related to just controlling all facets of reproductive care and reproductive rights.
Priyanka Aribindi: Absolutely.
Juanita Tolliver: Now, turning to a tragic story out of Owasso, Oklahoma that’s been all over the news. And that we want to give you more context around. A 16 year old non-binary student, Nex Benedict died one day after a fight in a school bathroom. According to an interview with The Independent, Nex’s mother, Susan Benedict, was called to the school on February 7th and found Nex quote, “badly beaten,” with bruises over their face and eyes and with scratches on the back of their head. She also shared that Nex told her that they were, quote, “knocked to the ground during the fight and hit their head on the floor.” Ms. Benedict told The Independent that she was furious that the school didn’t call an ambulance, and that she took Nex to the Bailey Medical Center in Owosso for treatment that day. She also spoke to a school resource officer while at the medical center. The next day, on February 8th, as Nex and Ms. Benedict were preparing to leave home for an appointment, Nex collapsed and they were declared dead later that evening at the hospital.
Priyanka Aribindi: Such a horrifying and scary situation and so deeply, deeply sad.
Juanita Tolliver: Yeah.
Priyanka Aribindi: What have school administrators and local police had to say in response to Nex’s death?
Juanita Tolliver: In a statement issued on February 20th, Owasso Public Schools acknowledged their limited public response to the fight and to Nex’s death have been out of respect for the ongoing police investigation, and they outlined updates in an effort to combat misinformation. Some of the most pertinent details include that each of the students involved in the altercation were seen by the school nurse, and while they determined that ambulatory care was not required, they did tell one parent to take their student to a medical facility for additional evaluation. The latest Owosso police statement, which was issued yesterday, confirmed that the student referred for additional medical evaluation was in fact Nex. The local police added that a complete autopsy had been performed and preliminary information from the medical examiner’s office quote, “indicated that the decedent did not die as a result of trauma.” They also stated that an official cause of death is pending toxicology results. There are still a lot of unknowns in this investigation, and the trauma of the loss of Nex’s life and the concerns for the safety and well-being of LGBTQ youth extend well beyond the Owasso community.
Priyanka Aribindi: Right. I mean, it’s no secret that Oklahoma has been targeting trans people in their latest legislative session. Can you describe the climate in the state right now, and how the social media account Libs of TikTok is related to this story? I know–
Juanita Tolliver: Right.
Priyanka Aribindi: –that that is a factor as well. Tell us more.
Juanita Tolliver: Let me put it this way Oklahoma state legislators are outperforming the rest of the country when it comes to harmful anti LGBTQ bills. According to the ACLU, Oklahoma is considering 54 anti-LGBTQ bills in the current legislative session. That’s the most in the whole nation. That includes everything from barriers to accurate IDs and health care age restrictions, to forced outing in schools, and book bans. And laws requiring students to use bathrooms that match their sex assigned at birth and restricting gender affirming care for minors took effect this year. So the environment is explicitly hostile for trans youth and LGBTQ people in Oklahoma. When it comes to Libs of TikTok, the creator of the account Chaya Raichik, is currently serving on Oklahoma’s library advisory board. And according to The Oklahoman, the TikTok account has been targeting LGBTQ friendly teachers and administrators in Owasso since 2022, even leading to one teacher’s resignation. Also, as people have been posting in response to Nex’s death, Raichik has been effectively trolling them, misgendering Nex and denying that her account has played any role in this tragedy.
Priyanka Aribindi: Yeah, this account seems to have a real penchant for doing this, taking things that are happening in specific areas of the country and just fanning the flames, inflaming the tensions.
Juanita Tolliver: Right.
Priyanka Aribindi: Inflaming everything and it’s scary, honestly. How have LGBTQ organizations been responding to this tragedy so far?
Juanita Tolliver: Tributes honoring Nex have been pouring in from local and national organizations like the Human Rights Campaign and Freedom Oklahoma. And organizations have been explicitly clear about the fact that Nex deserves to be alive right now. And Nex’s mother Susan Benedict said to The Independent, they were a straight-A student, devoted to their cat Zeus, and loved to draw and play Minecraft. This is still a developing story that we plan to get to the bottom of for you. And we know that learning about these tragic stories and the ways that LGBTQ people are targeted across the nation can be draining both mentally and emotionally. And we’ve linked to resources for support in our show notes. That’s the latest for now. We’ll be back after some ads. [music break]
[AD BREAK]
Priyanka Aribindi: Let’s wrap up with some headlines.
[sung] Headlines.
Priyanka Aribindi: Though the Biden administration fumbled the Fafsa overhaul, they continue to deliver on student loan relief. The White House yesterday wiped out $1.2 billion in debt for nearly 153,000 borrowers, all of whom enrolled in the Save plan. That is the relatively new student loan payment program Biden’s administration started. Here is the president speaking yesterday while he was fundraising in LA.
[clip of President Joe Biden] Folks, I’m happy to have been able to forgive these loans because when we realize and relieve Americans of their student debt, they’re free to chase their dreams.
Juanita Tolliver: Yeah, that’s what this has been about the entire time. Relieve the pressure. Give people the freedom to choose the life they want.
Priyanka Aribindi: Absolutely. And only one candidate for president is saying this right now. Just so you know.
Juanita Tolliver: Ding ding ding ding ding. [laugh]
Priyanka Aribindi: Those who will benefit started to get emails yesterday, they were told that it’s automatic so they don’t need to do anything else. So far, President Biden has helped nearly 4 million Americans by canceling $138 billion of their student debt. This is the kind of cancel culture that we can get behind.
Juanita Tolliver: Yeah, and I cannot imagine the relief that people getting that email must feel like, $0 due has to feel really great.
Priyanka Aribindi: Relief, elation. We love it. We love it for these people. So exciting.
Juanita Tolliver: And London’s High Court will decide what’s next for Wikileaks founder Julian Assange, after a two day hearing to appeal his extradition to the United States concluded yesterday. Assange has been indicted on espionage charges for publishing a trove of leaked military and diplomatic documents in 2010, including documents that his supporters say helped expose civilian deaths in the wars in Iraq and Afghanistan. He spent the last five years in a London prison, exhausting every avenue to avoid being brought to the US to face those charges and the potential 175 year prison sentence that they carry. After this week’s appeal, in which his lawyers claim the case against Assange was politically motivated, he may be out of options. For their part, lawyers for the US have urged the London court to block the appeal. They say Assange will be prosecuted for putting lives at risk, not for his political opinions. According to the Associated Press, we won’t know how the UK court rules until March at the earliest.
Priyanka Aribindi: The greatness of the Boeing name has finally been restored.
Juanita Tolliver: Has it? [laughing]
Priyanka Aribindi: No, no, it’s just a catchy headline. The company said yesterday that it had removed the executive in charge of its 737 Max program. Ed Clark previously worked at Boeing for almost 18 years, and his ouster comes after an incident last month in which the nightmares of many nervous fliers came true. A large piece of a 737 Max fell off mid-flight, leaving a gaping hole in the plane’s cabin. But it’s not like it was smooth flying with the 737 Max before all of this, you may remember that two of these planes crashed in 2018 and 2019. There is more news, if this week’s corporate reshuffling isn’t enough to get you back on Team Boeing. The Federal Aviation Administration is currently working through a six week audit of the company’s practices, which could lead to further safety reforms. If the Boeing stans on our team are still around in six weeks. I’m sure you’ll be hearing about it.
Juanita Tolliver: Yeah.
Priyanka Aribindi: With even more Boeing PR.
Juanita Tolliver: I also think we need more than safety reforms. We need some fines. Like once you fine people, they will not repeat this behavior. And the Republican led impeachment inquiry against President Biden continues to sputter through the House. Yesterday, the Oversight and Judiciary committees heard a closed door deposition from President Biden’s younger brother, James, who denied that the president had any involvement in his business deals. The president’s son, Hunter Biden, who has been at the center of the inquiry, will appear before the House next week. But this whole thing’s pretty much running on fumes after the former FBI informant, whose claims lay at the center of this inquiry, was charged by special Counsel David Weiss with making false statements. That informant made the explosive allegation that President Biden and his son received bribes from the Ukrainian energy company Burisma. But according to prosecutors, the informant now says that Russian intelligence officials passed along those fake claims. Okay, we got Russian interference, part 2.0 on the record now with this FBI informant. And you know what? Republicans aren’t going to stop with this complete sham impeachment effort.
Priyanka Aribindi: Nope.
Juanita Tolliver: And those are the headlines.
[AD BREAK]
Priyanka Aribindi: That is all for today. If you like the show, make sure you subscribe. Leave a review. Get back on Team Boeing if you dare. Who wrote this Boeing propaganda? And tell your friends to listen.
Juanita Tolliver: And if you’re into reading and not just emails that say no student debt like me, What a Day is also a nightly newsletter. Check it out and subscribe at crooked.com/subscribe. I’m Juanita Tolliver.
Priyanka Aribindi: I’m Priyanka Aribindi.
[spoken together] And we’ll see you on the country charts.
Priyanka Aribindi: Yes we will.
Juanita Tolliver: The best thing about Beyoncé on the country charts is the fact that there are more Black Country artists getting shine right now, like, it’s fabulous to see, I love it.
Priyanka Aribindi: Absolutely love it. So very exciting. Don’t know if we’ll ever make it, but we’ll always [laughter] have something to aspire to. [music break]
Juanita Tolliver: What a Day is a production of Crooked Media. It’s recorded and mixed by Bill Lancz. Our associate producers are Raven Yamamoto and Natalie Bettendorf. We had production help today from Jon Millstein, Greg Walters, and Julia Claire. Our showrunner is Leo Duran, and our executive producer is Adriene Hill. Our theme music is by Colin Gilliard and Kashaka.
[AD BREAK]